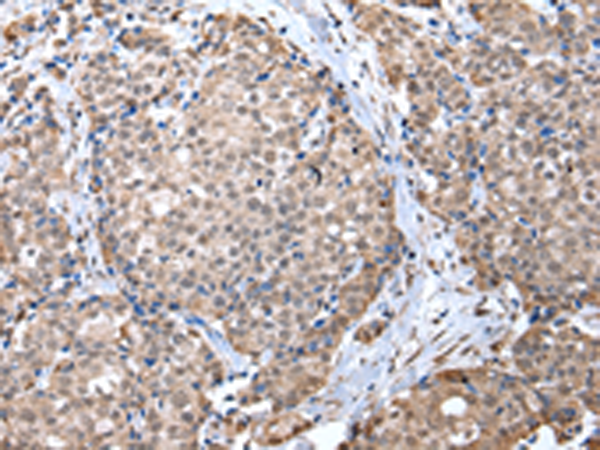

中文名稱 : 兔抗ZFP91多克隆抗體
|
Background: |
The protein encoded by this gene is a member of the zinc finger family of proteins. The gene product contains C2H2-type domains, which are the classical zinc finger domains found in numerous nucleic acid-binding proteins. This protein functions as a regulator of the non-canonical NF-kappaB pathway in lymphotoxin-beta receptor signaling. Alternative splicing results in multiple transcript variants. A read-through transcript variant composed of ZFP91 and the downstream CNTF gene sequence has been identified, but it is thought to be non-coding. Read-through transcription of ZFP91 and CNTF has also been observed in mouse. A ZFP91-related pseudogene has also been identified on chromosome 2. |
|
Applications: |
ELISA, IHC |
|
Name of antibody: |
ZFP91 |
|
Immunogen: |
Fusion protein of human ZFP91 |
|
Full name: |
ZFP91 zinc finger protein |
|
Synonyms: |
PZF; DMS-8; DSM-8; FKSG11; ZFP-91; ZNF757 |
|
SwissProt: |
Q96JP5 |
|
ELISA Recommended dilution: |
2000-5000 |
|
IHC positive control: |
Human lung cancer |
|
IHC Recommend dilution: |
25-100 |
購物車
幫助
021-54845833/15800441009
